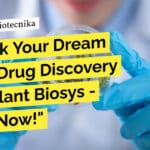
Jubilant Biosys Discovery Biology Research Associate Recruitment – Mol Bio, Genetics, Life Sciences Apply "Unlock Your Dream Job in Drug Discovery at Jubilant Biosys - Apply Now!"

Home Search
biology - search results
If you're not happy with the results, please do another search
Reliance Industries Recruitment! Biology Research Scientist Opportunity – Apply Now
Reliance Industries Careers Biology Research Scientist Opportunity - Apply Now
Research Scientist
Posted Date: 14 Mar 2024
Function/Business Area: Research & Development
Location: Vadodara
Job Responsibilities:
Ensure completion...
Institute of Science, Nirma University – Admission Open 2024 For MSc Biotech, Biochem &...
Nirma University Admissions 2024 Open at the Institute of Science, For MSc Biotech, Biochem & Microbiology Programmes
The Institute of Science
Established in 2004, the Institute...
NIMHANS Opportunity! BTech & MSc Biotech, Biochem, Genetics, Microbiology JRF/Project Recruitment
NIMHANS Hiring BTech & MSc Biotech, Biochem, Genetics, Microbiology JRF/Project Recruitment
NATIONAL INSTITUTE OF MENTAL HEALTH AND NEURO SCIENCES
Institute of National Importance, Hosur Road, Bengaluru...
Presidency University Job With Rs. 45,000 pm Pay for MSc Biology – Apply Now
Presidency University MSc Biology Project Job - Apply Now
Advertisement for a Junior Research Fellow position for a DST-SERB Funded Project at the Institute of...
Syngene Biocon-Bristol Myers Squibb R&D Center Hiring MSc, MTech Biotech, Biology, Biochem For Research...
Syngene Biocon-Bristol Myers Squibb R&D Center Hiring MSc, MTech Biotech, Biology, Biochem For Research Associate Job
BBRC
WE ARE HIRING
Senior Research Associate - Clinical Flowcytometry...
Walk-In Drive at Intas Pharmaceuticals For MSc Microbiology – QC Vacancies Available
Walk-In Drive at Intas Pharmaceuticals For MSc Microbiology - QC Vacancies Available
INTAS
Be a Part of a Winning Team
As one of the world's leading pharmaceutical...
MAHE Manipal Molecular Biology Project Scientist Job With Rs. 61,000 pm Pay – Apply...
MAHE Manipal Molecular Biology Project Scientist Job With Rs. 61,000 pm Pay - Apply Now
Project Research Scientist I
Manipal Academy of Higher Education (MAHE), Manipal,...
Cipla BSc Jobs – Microbiology Apply Online For Team Member Role
Cipla BSc Jobs - Microbiology Apply Online For Team Member Role
Junior Team Member - Microbiology
Requisition ID:83096
Posted: 13 Mar 2024
Job Description
Division: Quality
Department: Quality
Employment Type: Permanent
Job...
Freshers Bioinformatics Jobs – Genetics, Mol Bio, Microbiology, Biotech & Biochem Apply at Clarivate
Freshers Bioinformatics Jobs - Genetics, Mol Bio, Microbiology, Biotech & Biochem Apply at Clarivate
Associate Content Editor – GENESEQ
We are looking for an Associate Content Editor to...
Fully Remote WFH Job at Thermo Fisher For BSc, MSc Molecular Biology – Apply...
Fully Remote WFH Job at Thermo Fisher For BSc, MSc Molecular Biology - Apply Online
Validation Application Scientist
Remote, India
Job Id: R-01229558
Job Type: Full time
Category:...
Beckman Coulter Life Sciences BSc Immunology, Biochem & Cell Biology Lab Coordinator Job
Beckman Coulter BSc Immunology, Biochem & Cell Biology Lab Coordinator Job
Laboratory Coordinator (Contract)
Beckman Coulter Life Sciences Bangalore, Karnataka, India
Category: Other
Job Id: R1260594
Location: Bangalore, Karnataka, India
Job...
SJRI-BIOCON FOUNDATION Project Associate Job for Mol & Microbiology, Apply Now
SJRI Bioinformatics Project Job - Mol Bio & Microbiology Apply Online
Project Associate - BICON FOUNDATION Project
Division/Project Title: BICON FOUNDATION Project
Contact Person: MS. Lincy Thomas
Contact...
CSIR-CFTRI MSc Biochem, Biotech & Microbiology Project Associate Recruitment – Apply Online
CSIR-CFTRI MSc Biochem Job, Biotech & Microbiology Project Associate Recruitment - Apply Online
CSIR-CFTRI MSc Biochem Job, Biotech & Microbiology Project Associate Recruitment - Apply...
Jubilant Biosys Discovery Biology Research Associate Recruitment – Mol Bio, Genetics, Life Sciences Apply
Jubilant Biosys Discovery Biology Research Associate Recruitment - Mol Bio, Genetics, Life Sciences Apply
Jubilant Biosys, Bangalore is hiring for Research Associate in Discovery Biology...
Namdhari Seeds Private Limited Microbiology Seed Health Analyst Recruitment – Apply Now
Namdhari Seeds Private Limited Microbiology Seed Health Analyst Recruitment - Apply Now
Title: Seed Health Analyst
Location: Bidadi, Bangalore
Experience: 2 - 4 years of experience
Education: M.Sc....